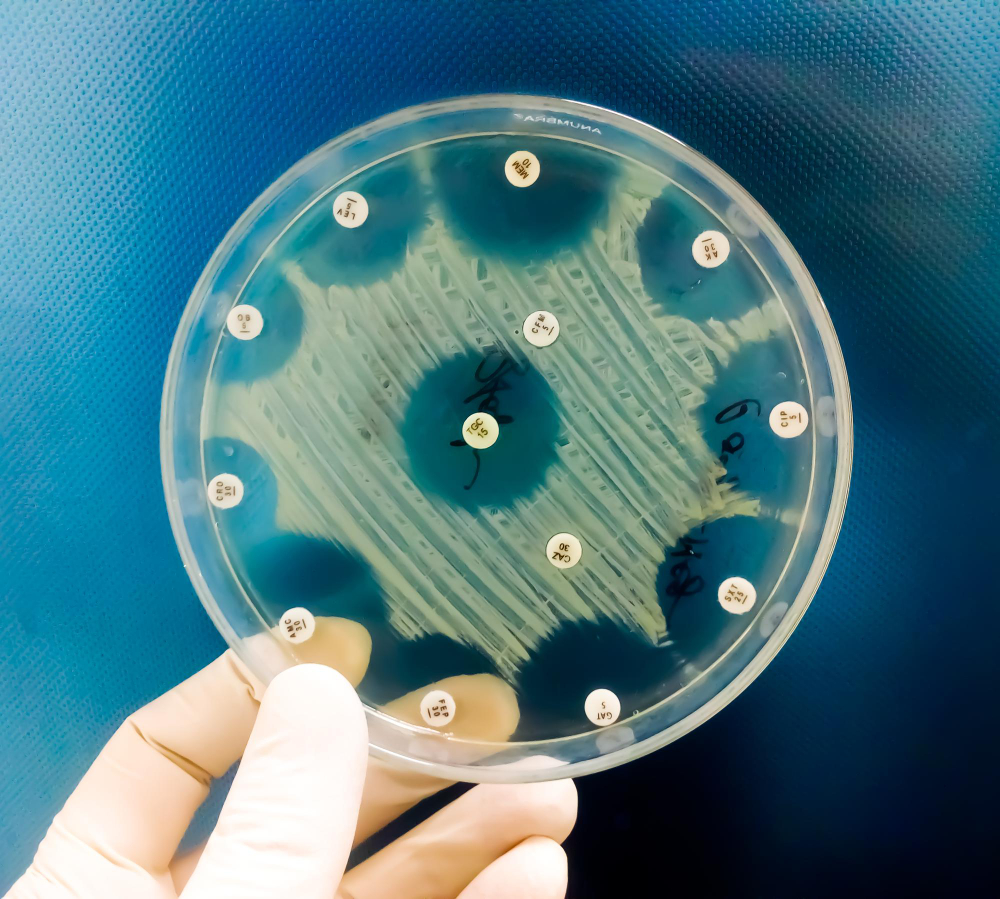

Diplomado en Bacteriología Clínica
y Resistencia Bacteriana
Los microorganismos, que en tiempos atrás eran sensibles a los antibióticos de uso común, en la actualidad la mayoría poseen múltiples genes de resistencia, que limitan grandemente a los especialistas en el momento de aplicar los tratamientos; en aquellos casos clínicos donde existía una infección de origen bacteriano.
Se propone aprovechar las investigaciones de los expertos para fortalecer la formación de profesionales y capacitarlos para que puedan ejercer sus labores en el campo de la medicina de la mejor manera posible; en esta ocasión específicamente en el procesamiento de cultivos bacteriológicos de forma manual y automatizada con la aplicación de las técnicas y procedimiento más adecuados novedosos, hecho que se traduzca en generar salud a los pacientes que en nuestro propósito principal como agente de cambio social.

Objetivos
Generales
- Actualizar a los participantes en la aplicación de las técnicas y los procedimientos más adecuados y novedosos en el procesamiento, seguimiento y diagnóstico de cultivo bacteriológico.
- Aplicación de técnicas que generan la determinación de mecanismo de resistencia a los antibióticos para realizar el antibiograma presentando el perfil de susceptibilidad correcto que sea de apoyo fundamental para el médico tratante.
Específicos
- Describir el procesamiento de muestras clínicas humanas para la identificación a través de procedimientos actualizados con pruebas de identificación bacterianas, con procedimientos especiales que permitan un correcto diagnóstico de los cultivos en estudio.
- La aplicación de las técnicas que generan la determinación de Mecanismos de resistencia a los antibióticos para realizar el antibiograma presentando el perfil de susceptibilidad correcto que sea de apoyo fundamental para el médico tratante.
- Presentar metodología anexas para la preparación y control de calidad de medios de cultivos y reactivos requeridos en el área de bacteriología clínica.

Nuestra Metodología
El desarrollo de los contenidos teóricos se realiza de forma sincrónica a través de videoconferencias, en la cual se desarrollara las bases teóricas, análisis de casos, discusiones y videos procedimentales.
La formación de los 4 primeros módulos estará acompañada con tareas de resoluciones de ejercicios y materiales de apoyo donde se deberán cumplir 90 horas teóricas.
Las horas practicas el estudiante las realizara en los Laboratorios internos (didácticos) en el área de nuestro Centro de Formación; la distribución será programada por coordinación y estará distribuida en grupos los cuales deberán cumplir 40 horas prácticas.
Filosofía Educativa
EL CENTRO DE FORMACIÓN CONTINUA DE EL SALVADOR, se inspira en un concepto de educación continua multidisciplinario el cual su finalidad es mantener a los profesionales actualizados con programas que beneficien a las diferentes disciplinas apegadas a las leyes de nuestro País amparándonos a la Ley General de Educación. Nuestros diplomados y cursos se encuentran respaldados por profesores especializados que cuentan con una sólida formación académica, así como con una amplia y reconocida experiencia.




Diplomado en Actualización en Hematología
Para Profesionales De Laboratorio Clínico
La hematología es el área que se enfoca en el estudio de la sangre y los tejidos que la producen. Los profesionales en esta área se enfocan en la detección temprana de enfermedades hematológicas.
Las enfermedades hematológicas son aquellas que afectan la producción y la función de los componentes de la sangre, como los glóbulos rojos, los glóbulos blancos, las plaquetas y los factores de coagulación. Algunas de las enfermedades hematológicas más comunes son la anemia, la leucemia, el linfoma, la hemofilia y la trombocitopenia.
La hematología, se encuentran en constante desarrollo con innumerables adelantos científicos, lo que ha tenido implicancias clínicas directas: mejora el diagnóstico, el seguimiento de las enfermedades con detección temprana de recaídas y sobre todo, los advenimientos de nuevos tratamientos

Nuestra Metodología
A través del diplomado, los profesionales reforzarán y adquirirán conocimientos relacionados al área de Hematología Diagnóstica, lo que le permitirá llevarlos a la vida diaria del laboratorio y así poder aportar un diagnóstico y tratamiento oportuno.
El diplomado está diseñado con una metodología teórico-practico, semipresencial, contando con docentes altamente calificados. La formación de los primeros módulos estará acompañada de tareas, casos clínicos y material de apoyo donde se deberán cumplir 90 horas teóricas.
Además, el profesional realizará sus prácticas en los Laboratorios internos (didácticos) en el área de nuestro Centro de Formación, la distribución será programada por coordinación y estará distribuida en grupos los cuales deben cumplir 40 horas prácticas.